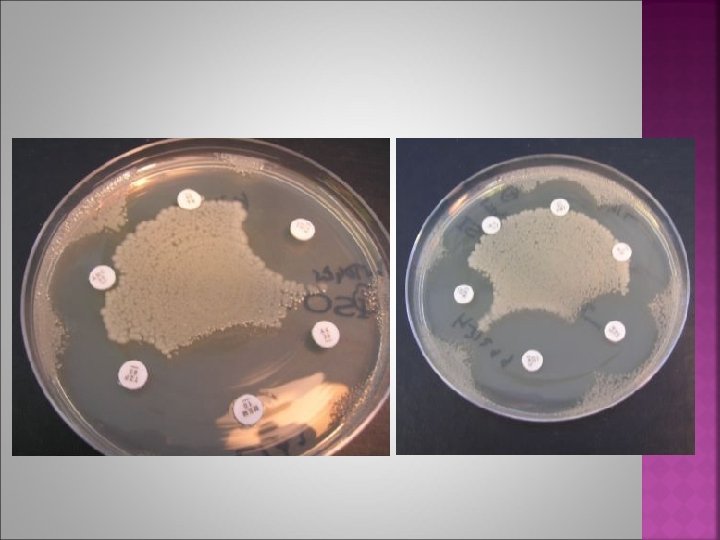

AGAR DIFFUSION METHOD BASMAH ALMAARIK Lab 2 ANTIBIOTIC

AGAR DIFFUSION METHOD BASMAH ALMAARIK Lab # 2

ANTIBIOTIC SENSITIVITY TEST Method 1) Broth dilution 2) Agar diffusion (solid) -a) Kirby-Bauer test (= disc test) - b) Stock’s methods

A) KIRBY-BAUER TEST (DISC DIFFUSION TEST) (SOLID AGAR TEST) Fresh organism suspended in broth. (0. 5 Ma. Cfaraland standard) Swab organism all over the plate evenly. Place discs containing specified concentration of different antibiotics on the plate.

KIRBY-BAUER TEST Incubate 37 C x 24 hr Measure diameter of Clear zone around the disc. (Inhibition zone) Use tables to assess if zone size indicates resistance or sensitivity to that antibiotic

KIRBY-BAUER TEST (DISC DIFFUSION TEST)

HOW TO STREAK THE SENSITIVITY PLATE Immerge swab then remove excess by pressing against wall of tube Do one line in the center of plate by swab then spread evenly Add antibiotic disks using needle Always work near flame to avoid contamination Don’t put disk near the edge

B) STOCKES METHOD Interpretation based on comparison between zones seen with the test organism & those of the known sensitive control. Q. C organism Antibiotic disk Test organism

RESULTS OF STOCKES METHOD T>C or T = C Sensitive T< C Resistance Test organism Control organism

http: //rfdp. seafdec. org. ph/publication/manual/antibiotics/chapter 2. html



Prepare 2 Kirby-Bauer technique plates: 1. Using disc dispenser 2. Using antibiotic ring technique Prepare 1 stocks method plate using control and test organisms given to you and inoculate 3 antibiotics using the needle. Next day: measure the inhibition zone in each plate and determine whether its sensitive or resistance by Zone Diameter Interpretative Standards

Thank You
- Slides: 14